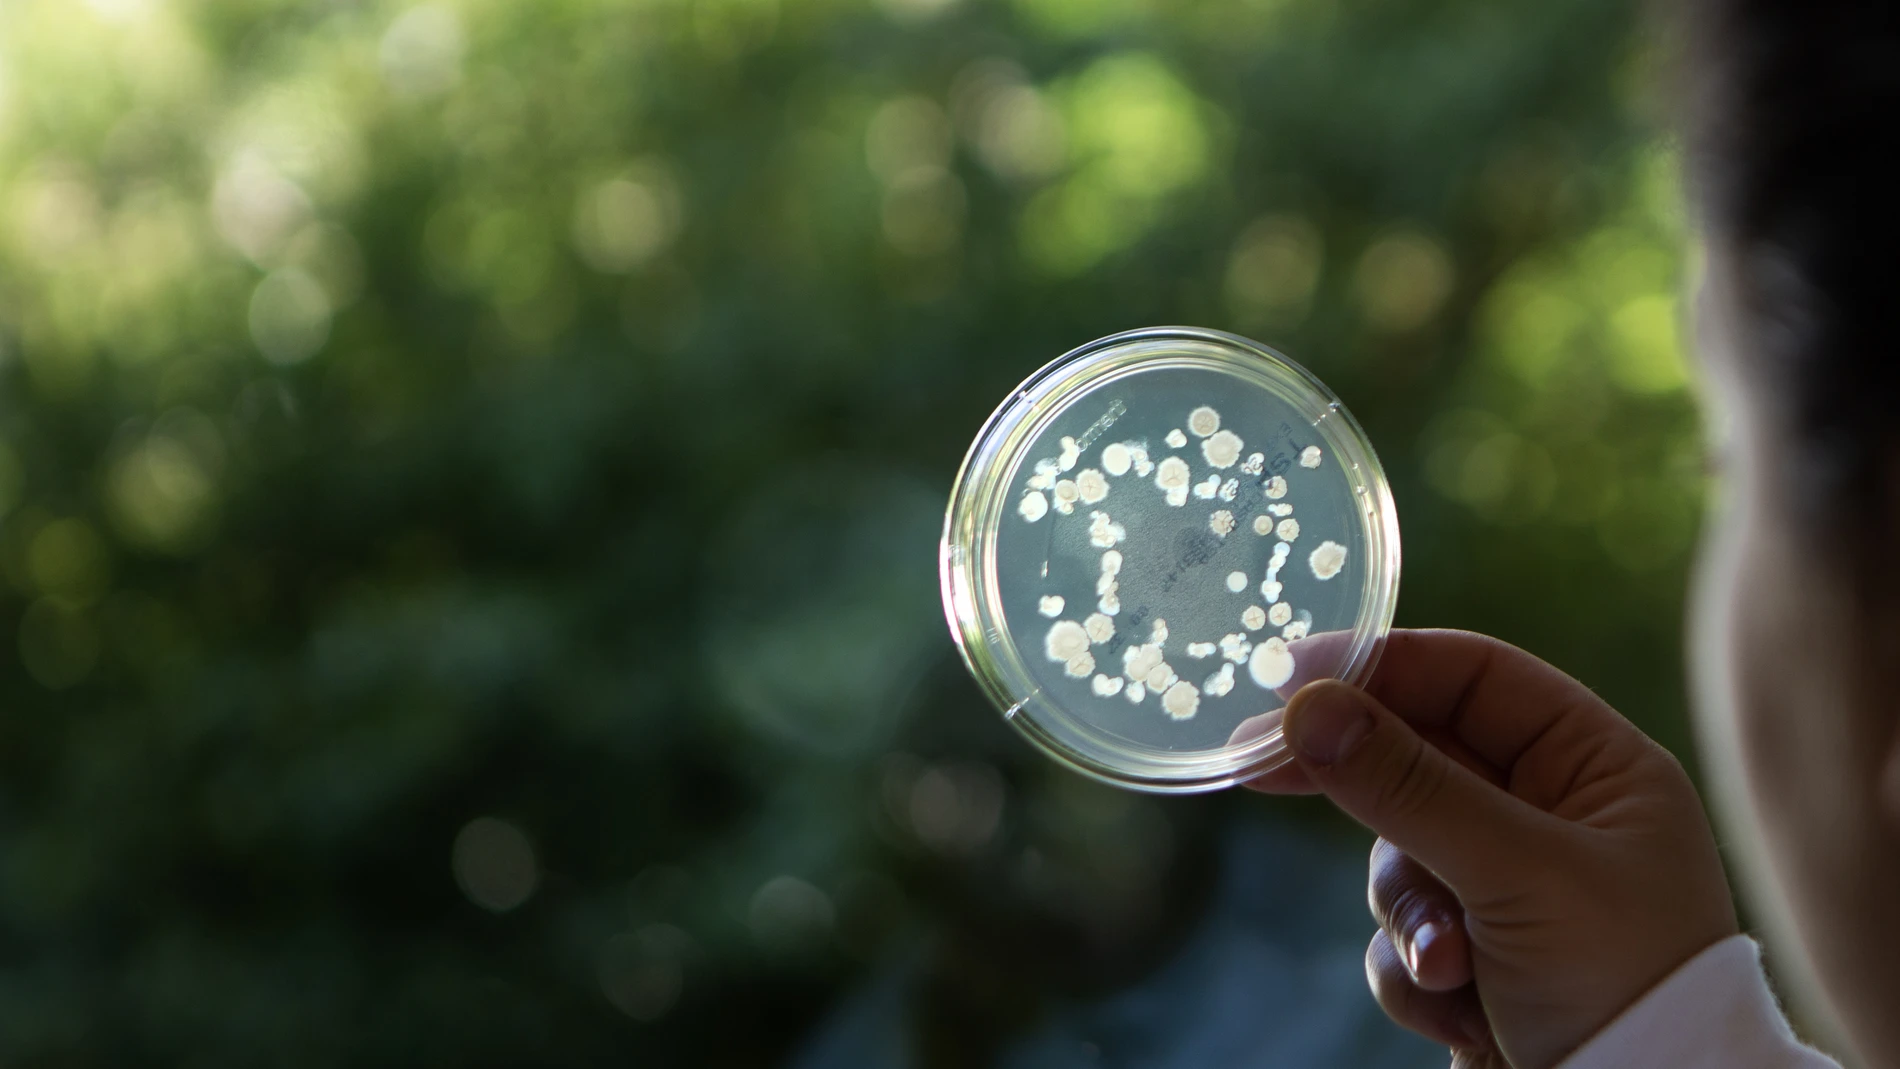
Plant Health_Formulation Lab_petridish

Today, one acre of US cropland can provide feed for the production of approximately 900 chickens.
A wide-ranging 2017 study showed that adding biosolutions to the agricultural value chain allows that same acre to continue feeding 900 chickens and, at the same time, provide 13 US gallons of biodiesel, 3 US gallons of starch-based ethanol, 32 pounds of protein-rich animal feed, 100 US gallons of cellulosic ethanol, and 230 kWh of electricity.
All while using less phosphorus and reducing greenhouse gas emissions. Now that’s real growth.